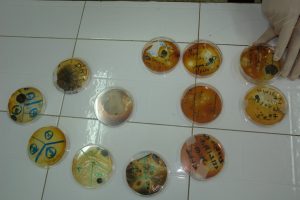
DSC00349 (Copier)

5.2K
تعمل مصلحة الترميم والتطهير في إطار الحفظ العلاجي للوثائق الأرشيفية من خلال ترميمها وتجليدها على مستوى مخبر الترميم وورشة التجليد باتباع خطوات علمية وعملية إنقاذ الأرصدة الأرشيفية المتضررة وفق المراحل التالية:
الفحص العيني أو الظاهري :
وذلك بمراقبة الأضرار الظاهرة على كافة جوانب الوثيقة من الشكل والحالة المادية وتسجيلها كملاحظات أولية للبدء في مراحل التحليل.
التشخيص الميكروبيولوجي :
تعد هذه المرحلة بمثابة نقطة بداية لعلاج الوثيقة من الآثار الظاهرة والحالة التي آلت إليها جراء عدة عوامل بيولوجية (البكتيريا ، الفطريات)، وفق الخطوات التالية:

يتم إعادة إجراء التحاليل الميكروبيولجية للوثائق للتأكد من مدى فعالية التعقيم للقضاء على البيكتيريا والفطريات.



معالجة الحموضة: إذا كانت درجة الحموضة مرتفعة فإن العلاج يكون ضروريا. بالنسبة للحبر الثابت تعالج الحموضة باستعمال المحاليل التالية :
– Hydroxide de calcium
– Hydroxide de magnesium







تخضع الوثيقة بعد تعقيمها للتنظيف إذ يتم ذلك بواسطة استعمال أدوات ومواد يتم تطبيقها على السطح وهو نوعان :
وذلك استعمال مسحوق الممحاة والمشرط والفرشاة الناعمة لإزالة العوالق الحشرية والأتربة.
ويكون باستخدام الماء المقطر أو الكحول النقي وذلك يخضع لقاعدة انحلال الحبر.
و التنظيف هو تفاعل كيميائي و فيزيائي باستطاعته نزع الاتساخ ويستوجب الخبرة العلمية و يعد جزء مهم في إطالة عمر الوثيقة .





يخضع الترميم لعدة مبادئ رئيسية أهمها الاحترام الشديد للوثيقة حتى لا يتم إتلافها أكثر أو تزييفها إذ يجب على المرمم التركيز واحترام المبادئ التالية:
















ينقسم الترميم إلى نوعين:
الترميم بالأصل عملية يدوية خاصة تتصل بقوة التحكم ومهارة العمل وجمالية التعامل مع المواد التاريخية بصفة عامة و المخطوطات خاصة باستخدام أدوات خاصة، ورغم التطور العلمي والتقني فإنه ما زال معروفا أن الترميم اليدوي هو أغلى أنواع الترميم وهو الحرفة النادرة في العالم و التي تعنى بإعادة الروح إلى المخطوطات القيمة وإرجاعها إلى أصلها وكذلك في المطبوعات والوثائق الثمينة.
يستخدم الترميم الآلي في حدود ضيقة بالنسبة للمخطوطات. وتتم بإستعمال جهاز خاص. وتعتمد فكرة الجهاز المستخدم على استعمال الألياف السيليلوزية الذائبة في الماء محسوبا وزنا و مساحة، ثم شفط هذا الخليط في الثقوب والمساحات الناقصة ليكون مساحات ورقية ، ثم تأتي بعد ذلك مرحلة التجفيف لوقت معين .
ويبدأ التجليد بعد الفراغ من ترميم الوثيقة ، إذ تجمع الأوراق على هيئة كراسات أو ملازم، ويتم خياطتها معا لتكوين كتلة المخطوط ويتم لصق الملازم أو الكراسات بالغراء، ثم يجري تبطينها وتركيب الغلاف وتشبيكها من جهة الكعب .
تمر عملية التجليد بعدة مراحل يمكن اختصارها ، بتثقيب الوثيقة أولا، ثم يمر بمرحلة الخياطة كمرحلة ثانية، وبعد الخياطة يتم صنع الغلاف وهو من الكارتون والجلد، لتنتهي المرحلة الأساسية بتجميع الوثيقة وذلك بوضعه في داخل الغلاف، وتجهيزه لعملية التذهيب وكتابة العنوان وما شابه وهي ليست من المراحل الضرورية فقط بل تكاد أن تكون كمالية جمالية تعكس عراقة الوثيقة.






